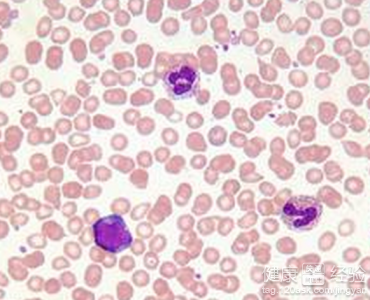
第2步

你好!自從過了五十歲以後就很容易傷感。特別是感覺人的年紀大了,傷春悲秋的時間越來越多。尤其是身邊的老年朋友越來越少的情況下更是非常容易觸動心靈中那脆弱的地方。最近好幾位認識的人就是在無征兆的情況下倒下去了。原因都是心肌梗死!他們之前都是那種看上去很健康的人,為什麼就得了心肌梗死呢。我想知道造成心肌梗死的覺原因是什麼?
1打個比方來說吧:人的血管是人身體中非常重要的運輸工具,它承擔著從心髒出發給全身輸送營養循環回心髒的重要作用。而且隨著人年齡的增加,身體變老。血管就像用久了的彈簧慢慢的開始出現的老化的情況。

2飲食不健康吃的垃圾食品太多,生活不規律,容易激動心情起伏過大,過於勞累,甚至天氣忽冷忽熱的環境變化等等都很容易造成血管出現老化。造成心髒的沉重負擔,從而造成人出現心肌梗死的情況。
3無意中碰撞比較厲害造成的內傷也很容易造成老人出現心肌梗死的情況,萬萬不能忽視。另外還有一種就是便秘的情況,也極容易造成心肌梗死。而做手術時突然大出血也極容易造成心肌梗死。這幾種是比較少見的情況
有條件的老人在身體不舒服時最好到醫院做下體檢。就算條件不是太好的也要爭取做到定期體檢。有問題早發現,生活中保持平靜的心態。不要讓自己過於勞累,多喝水果和蔬菜,堅持做些力所能及的運動。愛惜自己的身體,才是對兒女最好的禮物